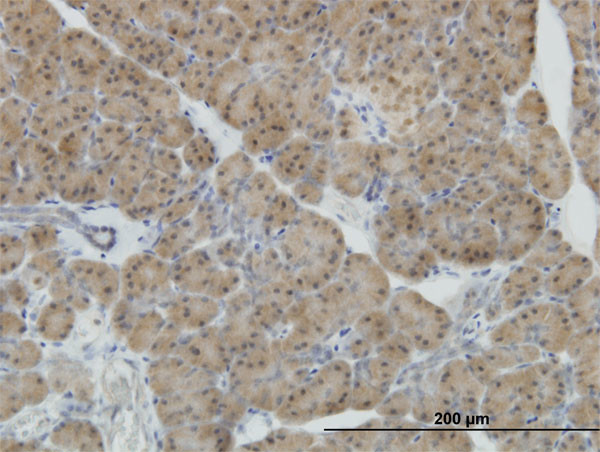
NEUROD1 Antibody in Immunohistochemistry (Paraffin) (IHC (P))

Search
Abnova
NEUROD1 Monoclonal Antibody (3D11)
{{$productOrderCtrl.translations['antibody.pdp.commerceCard.promotion.promotions']}}
{{$productOrderCtrl.translations['antibody.pdp.commerceCard.promotion.viewpromo']}}
{{$productOrderCtrl.translations['antibody.pdp.commerceCard.promotion.promocode']}}: {{promo.promoCode}} {{promo.promoTitle}} {{promo.promoDescription}}. {{$productOrderCtrl.translations['antibody.pdp.commerceCard.promotion.learnmore']}}
产品信息
H00004760-M02
宿主/亚型
分类
类型
克隆号
抗原
偶联物
形式
浓度
规格
保存条件
运输条件
产品详细信息
Sequence of this protein is as follows: QDMPPHLPTA SASFPVHPYS YQSPGLPSPP YGTMDSSHVF HVKPPPHAYS AALEPFFESP LTDCTSPSFD GPLSPPLSIN GNFSFKHEPS AEFEKNYAFT
靶标信息
NeuroD1 is a transcriptional activator that acts as a differentiation factor during neurogenesis. It has been demonstrated to bind to the insulin gene E-box. Efficient DNA binding requires dimerization with another basic helix-loop-helix (bHLH) protein. Defects in NEUROD1 are a cause of maturity onset diabetes of the young type VI (MODY6). MODY6 is a form of non-insulin-dependent diabetes mellitus characterized by an autosomal dominant mode of inheritance, onset during young adulthood and a primary defect in insulin secretion.
仅用于科研。不用于诊断过程。未经明确授权不得转售。